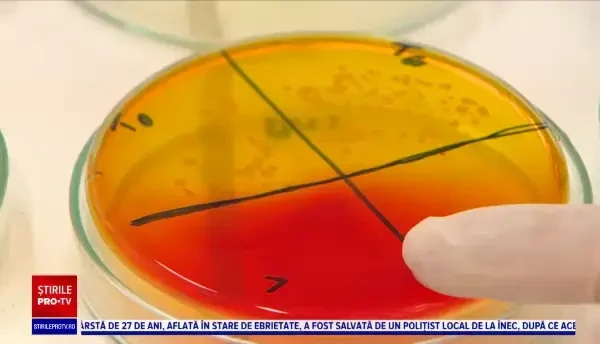
Cât de periculoase sunt bacteriile de pe telefoanele mobile. Descoperire alarmantă a specialiștilor

Incidența COVID în România. Este prima dată de la începutul pandemiei când Capitala nu înregistrează noi infectări

Doliu în Bavaria, după ce un migrant somalez a ucis trei oameni și a rănit grav alți cinci. Ce le-a spus atacatorul vecinilor

Meșterii olari s-au adunat la Târgul Național de Ceramică, de la Iași. Care au fost cele mai căutate vase de lut

Un grup de motocicliști cu suflet mare ajută oamenii sărmani și vârstnicii singuri din București. ”Am zis să facem de drag”

Om de afaceri turc, expulzat din România. Judecătorii l-au declarat indezirabil din raţiuni de securitate naţională

Cod roșu de distracție în București. Unii au dansat în Centrul Vechi, în timp ce alții au recitat poezii în Grădina Botanică